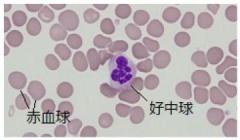

文字サイズ
検体検査は、血液や尿などの検体で検査します。
病気の診断とその経過や重症度を判定するのに利用されています。
検査は、最新の自動分析器や専門技術を使用し正確で迅速に行っています。
院内で検査可能な全ての検査に関して24時間対応をしています。(一部の検査を除く)
ALT、AST、γGTPなどの肝機能・腎機能検査をしています。
また血糖、HbA1cなど糖尿病関連の検査もしています。


腫瘍マーカー、感染症などの免疫学的検査をします。
赤血球数、白血球分類、凝固因子、出血傾向など血球の成分、数、機能の検査をします。

ABO、Rh型、不規則抗体検査、血液型などの検査をします。


検査のための採血と検体受付をします。

尿検査、便検査などをします。

